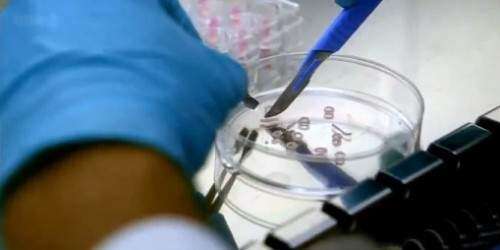

El subdirector de la Oficina de Epidemiología e Investigación, Julio Cadiz Velázquez, desmintió esta tarde información que circulaba en las redes sociales alegando la presencia de la bacteria Vibro Vulnificus en varias playas de la isla.
‘Hasta el momento, no se ha reportado ningún caso de esta bacteria en Puerto Rico y la probabilidad de que la misma llegue a nuestras aguas es sumamente remota. Las personas no tienen nada de qué preocuparse al acudir a la playa’, sentenció Cadiz Velázquez.
El epidemiólogo explicó que en los estados del Golfo, como la Florida, sí se han reportado casos, por lo que advirtió a viajeros a cubrirse heridas abiertas cuando vayan a la playa. Además, indicó que la bacteria se transmite principalmente al consumir ostiones crudos y recomendó solamente consumirlos cocidos.

Imagen de una de las publicaciones engañosas de en Facebook que alertan sobre la bacteria. (Facebook)

Empieza a crear una cuenta
Te enviaremos un correo electrónico con un enlace para verificar tu cuenta. Si no lo ves, revisa tu carpeta de correo no deseado y confirma que tienes una cuenta vinculada a ese correo.
Introduce el correo electrónico de tu cuenta y te enviaremos un enlace para restablecer la contraseña.
Le hemos enviado un correo electrónico a {{ email }} con un enlace para restablecer su contraseña. Si no lo ve, revise su carpeta de correo no deseado y confírmeme que tiene una cuenta vinculada a ese correo electrónico.
Verifica que tu dirección de correo electrónico sea correcta. Una vez completado el cambio, utiliza este correo electrónico para iniciar sesión y administrar tu perfil.
Comentarios {{ comments_count }}
Añadir comentario{{ child.content }}